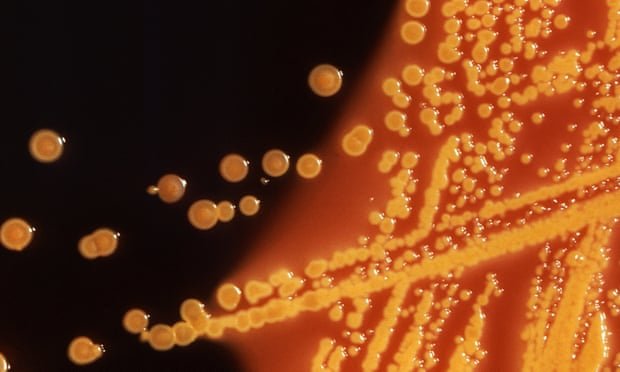

O micróbio vivo, feito em laboratório, que possui um código de DNA totalmente sintético, é o primeiro desse tipo já criado.
O avanço foi feito por pesquisadores do laboratório de biologia molecular da Universidade de Cambridge, que redesenhou o DNA de E Coli – uma cepa comumente encontrada de bactérias.
O trabalho envolveu até 18.000 edições no genoma, depois sintetizando quimicamente o novo código genético e adicionando-o à bactéria pedaço por pedaço até que tivesse substituído seu genoma natural.
A criação resultante é muito semelhante à sua contraparte natural, mas é inteiramente sintética e sobrevive em um conjunto muito menor de instruções genéticas.
A conquista representa um passo importante para a criação de organismos artificiais capazes de realizar várias tarefas benéficas dentro do corpo humano, como a defesa contra vírus.
“Eles levaram o campo da genômica sintética a um novo patamar, não apenas construindo com sucesso o maior genoma sintético até hoje, mas também realizando as mais importantes mudanças no genoma até agora”, disse o pesquisador de biologia sintética Tom Ellis, do Imperial College London